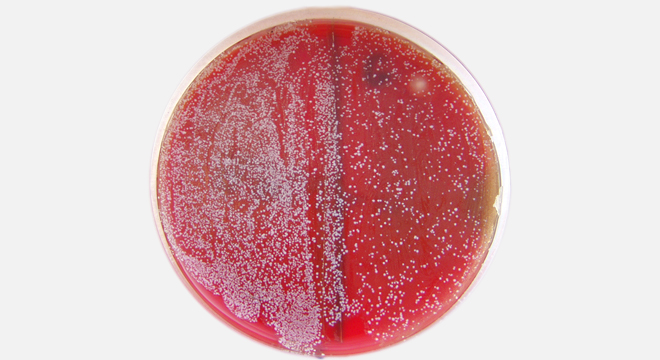

Mundsoor ist eine Infektion der Mundschleimhaut, die durch Hefepilze, meistens durch Candida albicans, verursacht wird.
Die Infektion tritt häufig bei Babys auf, weil ihre Hautbesiedelung mit gutartigen Keimen, die mit den Pilzen konkurrenzieren, noch nicht so gut ausgebildet ist.
Typische Kennzeichen der Erkrankung sind ein weisser Belag sowie krümelige Auflagerungen auf der Wangenschleimhaut und auf der Zunge. Es können auch andere Organe, wie zum Beispiel die Speiseröhre, der Magen-Darm-Trakt oder der Genitalbereich von der Pilzinfektion betroffen sein.
Bei Babys, die an Mundsoor erkranken, kommt es häufig zu einer zusätzlichen Pilzinfektion im Windelbereich, dem so genannten Windelsoor.